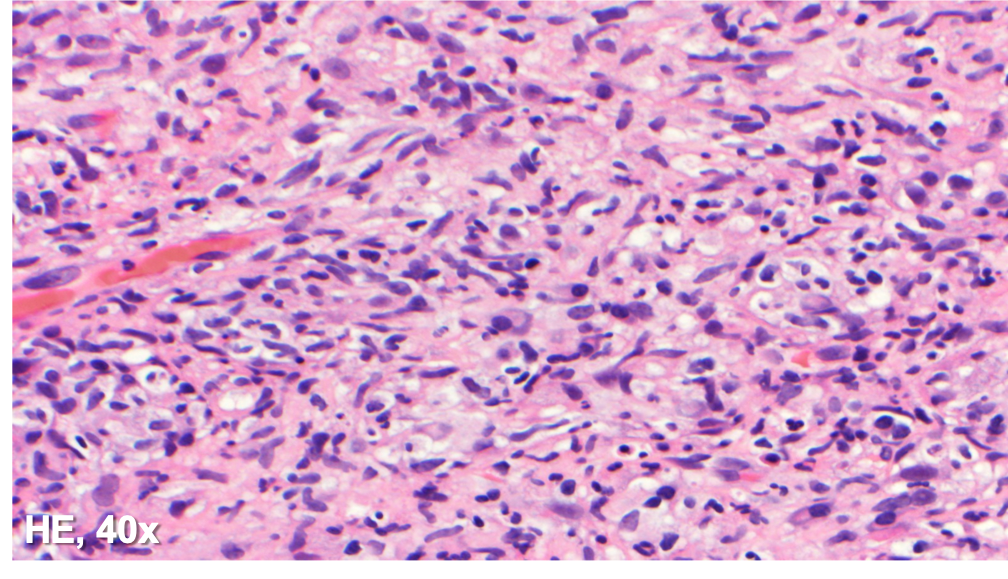
Picture4

Case History
A 36-year-old HIV+ male with left retroperitoneal adenopathy. Prior h/o sepsis and negative excisional biopsy. What is the diagnosis?
- Metastatic carcinoma
- Lymphoproliferative neoplasm
- Infectious lymphadenidits
- HIV lymphadenitis
The answer is “C”, Infectious lymphadenitis.




The specimen shows a tissue core with a diffuse histiocytic proliferation and scattered plasma cells. No lymph node architecture is identified. Many of the cells are plump and with abundant foamy cytoplasm, while others appear spindled in morphology.
Immunoperoxidase and special stains were performed on this case. The cells were diffusely positive for CD45 and CD163, and negative for keratin cocktain, S100, CD1a and CD30. AFB and Fite were positive for acid fast bacilli, and highlighted abundant organisms. The findings were consistent with an infectious lymphadenitis, and most suggestive of a nontuberculous mycobacterial infection.
In a young patient with a history of HIV and prior sepsis, an infectious lymphadenitis should be considered highly in the differential diagnosis. Bacterial lymphadenitis caused by Mycobacterium tuberculosis is generally characterized by necrotizing granulomatous inflammation, with the bacilli localized within the necrotic area. Atypical mycobacterial lymphadenitis is the result of nontuberculous mycobacteria, and nearly 80% are caused by Mycobacterium avium-intracellulare complex (MAC). The main histologic finding includes the coexistence of necrotizing and nonnecrotizing granulomatous inflammation with abundant bacterial organisms within the foamy macrophages. Additionally, a mycobacterial spindle cell psuedotumor can present as granulomatous inflammation in response to the infection by mycobacterial organisms; the histiocytes exhibit a spindle cell morphology, forming fascicles with or without whorling.
The lymphoproliferative neoplasms that develop in association with HIV infection are predominantly aggressive B-cell lymphomas, the most common being Burkitt lymphoma, diffuse large B-cell lymphoma, primary effusion lymphoma and plasmablastic lymphoma. They have a predilection for extranodal sites, particularly the gastrointestinal tract, liver, and bone marrow.
HIV lymphadenitis shows 3 morphologic patterns. Pattern A shows florid follicular hyperplasia; pattern C is characterized by lymphocyte depletion with atrophic and burned-out follicles; and pattern B shows a mixture between patterns A and C.
References
Miranda RN, Khoury JD, Medeiros LJ. Atlas of Lymph Node Pathology. New York, NY: Springer; 2013.
Case contributed by: Frida Rosenblum, M.D., Assistant Professor, Anatomic Pathology